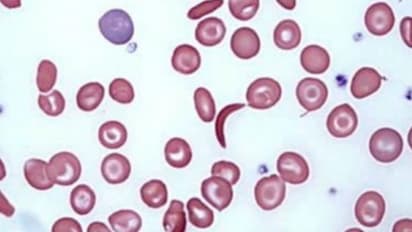
Anemia In Men : ಪುರುಷರಲ್ಲಿ ಅನೀಮಿಯಾ ಸಮಸ್ಯೆ, ಈ ಲಕ್ಷಣಗಳನ್ನು ಇಗ್ನೋರ್ ಮಾಡ್ಬೇಡಿ

Anemia In Men : ಪುರುಷರಲ್ಲಿ ಅನೀಮಿಯಾ ಸಮಸ್ಯೆ, ಈ ಲಕ್ಷಣಗಳನ್ನು ಇಗ್ನೋರ್ ಮಾಡ್ಬೇಡಿ
Suvarna News | Asianet News
Published : Dec 24, 2021, 06:30 PM ISTರಕ್ತಹೀನತೆ (anemia )ಮಹಿಳೆಯರಲ್ಲಿ ಮಾತ್ರವಲ್ಲದೆ ಪುರುಷರಲ್ಲೂ ಉಂಟಾಗಬಹುದು. ಇತ್ತೀಚಿನ ರಕ್ತಹೀನತೆಯ ಪ್ರಕರಣಗಳು ಪುರುಷರಲ್ಲಿ ವೇಗವಾಗಿ ಹೆಚ್ಚಿವೆ, ಆದ್ದರಿಂದ ಅದರ ರೋಗಲಕ್ಷಣಗಳನ್ನು ತಿಳಿದುಕೊಳ್ಳುವುದು ಮುಖ್ಯ. ಈ ರೋಗಲಕ್ಷಣಗಳನ್ನು ನೀವು ಗಮನಿಸಿದರೆ, ಅವುಗಳನ್ನು ನಿರ್ಲಕ್ಷಿಸಬೇಡಿ.
ಆರೋಗ್ಯ, ಸೌಂದರ್ಯ, ಫಿಟ್ನೆಸ್, ಕಿಚನ್ ಟಿಪ್ಸ್, ಸಂಬಂಧ, ಫ್ಯಾಷನ್, ರೆಸಿಪಿ ಅಪ್ಡೇಟ್ಗಳಿಗಾಗಿ ಏಷ್ಯಾನೆಟ್ ಸುವರ್ಣ ನ್ಯೂಸ್ ಫಾಲೋ ಮಾಡಿ. ಸಂಪೂರ್ಣ ಮಾಹಿತಿ ಒಂದೇ ಕ್ಲಿಕ್ನಲ್ಲಿ ಲಭ್ಯ. ಏಷ್ಯಾನೆಟ್ ಸುವರ್ಣ ನ್ಯೂಸ್ ಅಧಿಕೃತ ಆ್ಯಪ್ ಡೌನ್ಲೋಡ್ ಮಾಡಿ ಹಾಗು ಎಲ್ಲಾ ಅಪ್ಡೇಟ್ ಗಳನ್ನು ಪಡೆಯಿರಿ.
click me!